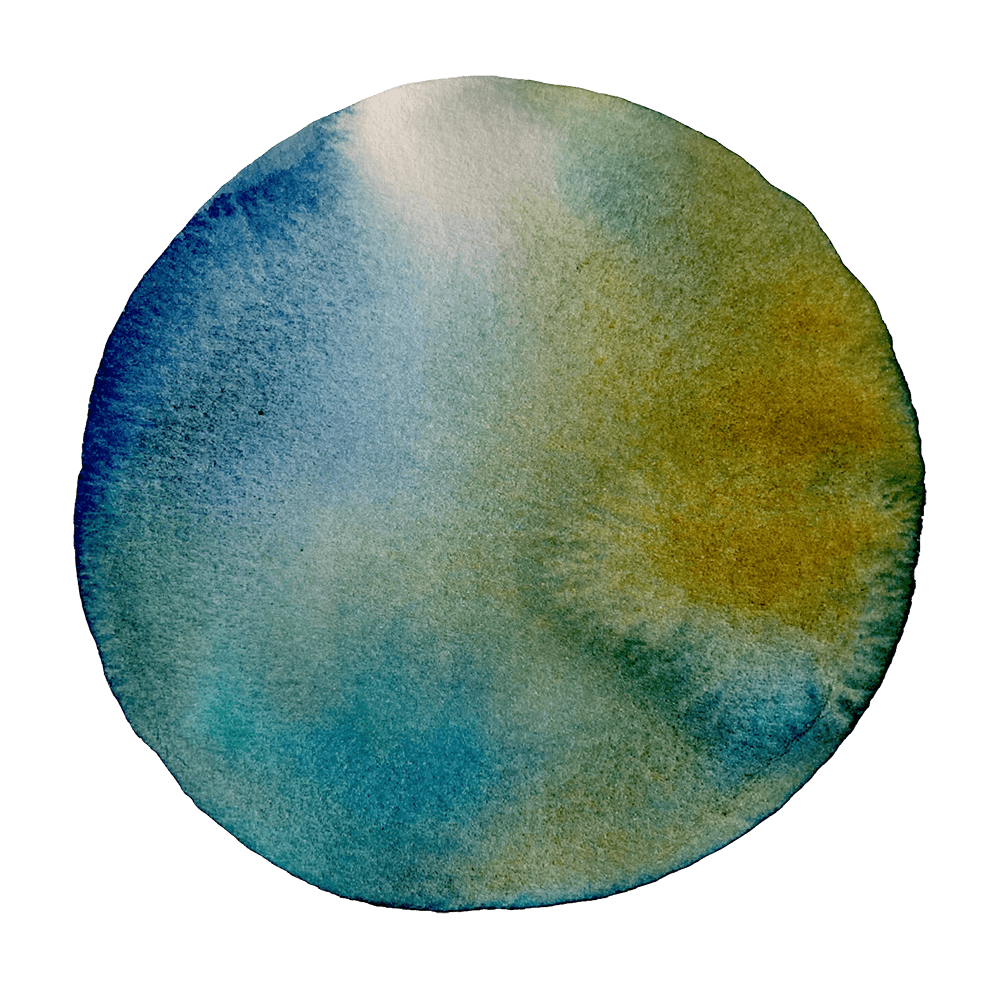

„Aber, ich kann nicht zeichnen!“
Die eigenen künstlerischen Fähigkeiten spielen dabei eine untergeordnete Rolle. Das Wichtige ist nicht das Resultat, sondern der Prozess. Wenn dabei etwas Schönes entsteht, ist das ein Bonus, jedoch kein Muss.
Oft ist das entstehende oder entstandene Produkt im gestalterischen Prozess flexibel und veränderbar. Das fertige Produkt kann ein Zwischenprodukt sein, wobei die Veränderung eines Bildes und die Veränderung der eigenen Wahrnehmung, des eigenen Erlebens miteinander einhergehen können.
Wichtig ist aber: Das Bild muss nicht gut aussehen und es muss keine Bedeutung haben.
„[…] so hatte ich 2012 meine erste Therapie im Südhang in Kirchlindach.
Da hiess es: „Herr K. heute Nachmittag ist Kunsttherapie.“ Darauf entgegnete ich: „Das ist nichts für mich. Ich kann nicht zeichnen, ich habe dazu keinen Bezug und ich kann das nicht.“, „Sie müssen.“
Also ging ich und sass dort, hatte ein unverschämt weisses Papier vor mir, und die anderen waren alle beschäftigt. Da dachte ich, was mache ich jetzt?
Nach einer Zeit sah ich ein Lineal herumliegen, also begann ich Linien zu ziehen. Ich weiss nicht mehr genau, was da genau passierte, jedenfalls packte es mich plötzlich und ich war fast jeden Abend im Atelier. […] Da fing es an und ich merkte, wie mir das Zeichnen richtig guttat. Es gibt kein Vorher, kein Nachher, nur ein Jetzt. Es ist für mich wie eine Meditation.“
Auszug aus einem Interview mit einem Patienten im Psychiatriezentrum Münsingen (PZM), im Zuge meiner Abschlussarbeit im Rahmen meiner Ausbildung zur intermedialen Kunsttherapeutin.